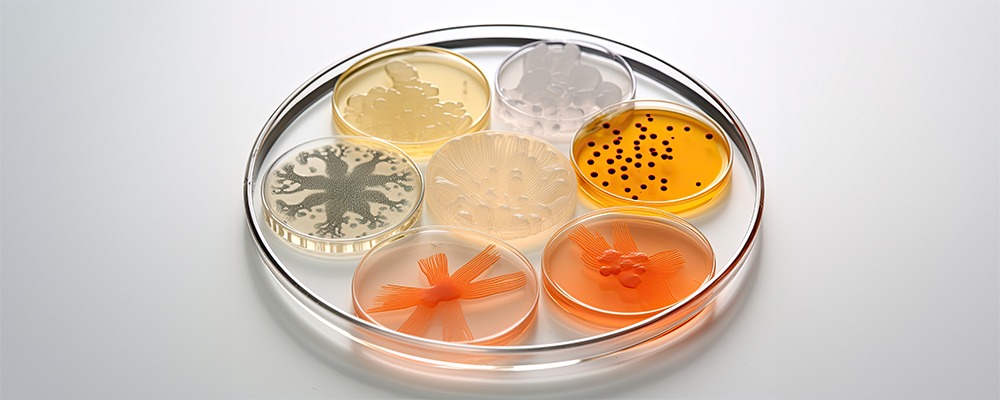

Pharmaceutical manufacturing has long been defined by complex chemical synthesis, rigorous quality checks, and a strong focus on innovation. As global health needs evolve and the demand for safer, more cost-effective medicines increases, the industry has started to look beyond traditional chemical processes to more sustainable alternatives. One such game-changing development has been the widespread adoption of enzymes in pharmaceutical manufacturing.
Enzymes, the natural catalysts of biological systems, are today at the heart of many industrial processes. From their ability to accelerate reactions under mild conditions to their role in reducing environmental impact, enzymes are now considered indispensable in pharmaceutical manufacturing. They provide a unique blend of efficiency, specificity, and eco-friendliness that is difficult to achieve through conventional chemistry.
The Rise of Biocatalysis in Pharmaceuticals
Biocatalysis, or the use of enzymes to drive chemical reactions, has become one of the most significant trends in pharmaceutical production. Unlike chemical catalysts that often require high temperatures, pressures, or hazardous reagents, enzymes operate under mild conditions and deliver remarkable results with minimal by-products.
This shift towards enzyme-driven processes is particularly relevant in the synthesis of active pharmaceutical ingredients (APIs). APIs often require multiple reaction steps and complex chiral structures, making their production time-consuming and costly. Enzymes, due to their inherent selectivity, can streamline these reactions and enhance yield while lowering costs. This has allowed pharmaceutical companies to produce life-saving drugs more efficiently, with less waste and improved sustainability.
Enzymes and Chiral Selectivity
One of the most compelling reasons enzymes have become essential in pharmaceutical manufacturing is their unparalleled ability to produce chiral molecules. Chirality is a critical aspect of drug development because many pharmaceutical compounds are chiral in nature, and only one enantiomer is therapeutically active.
Traditional chemical synthesis often results in racemic mixtures, which means additional steps are required to separate the desired enantiomer from its mirror image. This separation is costly and inefficient. Enzymes, however, are naturally selective. They can target and produce the correct enantiomer with high precision, reducing the need for post-reaction purification.
As regulatory bodies across the globe emphasise quality and safety, enzyme-based synthesis ensures greater compliance with these standards by producing cleaner, more predictable outcomes.
Cost Efficiency and Sustainability

The pharmaceutical industry is increasingly focused on reducing costs without compromising quality. Enzymes play a vital role in achieving this balance. Their ability to function at ambient temperatures and pressures significantly reduces energy consumption during production. Furthermore, because enzyme-driven processes often use water as a solvent, the need for harmful organic solvents is minimised, lowering both cost and environmental impact.
Sustainability has become more than just a trend in modern manufacturing. It is now a necessity. Governments and stakeholders expect pharmaceutical companies to adopt greener technologies and minimise their carbon footprint. Enzyme-based processes address these concerns by offering an environmentally friendly alternative that reduces chemical waste and promotes pollution-free practices.
Applications of Enzymes in Pharmaceutical Manufacturing
The role of enzymes in pharmaceutical manufacturing is broad and diverse. Some of the most significant applications include:
- API Synthesis: Enzymes are widely used to catalyse key reactions in the production of APIs, helping companies develop drugs more efficiently.
- Drug Modification: Enzymes facilitate modifications that enhance solubility, stability, and bioavailability of compounds, making them more effective.
- Enzyme Therapy: Certain enzymes themselves act as therapeutic agents, such as in the treatment of enzyme deficiency disorders.
- Green Chemistry: Enzymes reduce the dependence on harsh reagents, aligning pharmaceutical production with green chemistry principles.
- Immobilised Enzymes: Immobilised enzyme systems provide higher stability and reusability, offering better control over pharmaceutical processes.
Enzymes in Antibiotic Production
One area where enzymes have made a particularly strong impact is antibiotic production. The biosynthesis of antibiotics often involves highly specific reactions that enzymes are well-suited to perform. By incorporating enzyme-based processes, manufacturers can achieve higher yields, fewer impurities, and a more cost-effective approach to production. This is crucial at a time when the demand for antibiotics is increasing, and the world faces the threat of antimicrobial resistance.
Enzymes as Therapeutic Agents
Beyond their use in manufacturing, enzymes are increasingly being developed as drugs themselves. Enzyme therapies have shown promise in treating metabolic disorders, genetic conditions, and cancers. For example, enzyme replacement therapies are now used to manage rare genetic diseases where patients lack specific enzymes. This demonstrates not only the versatility of enzymes in drug production but also their potential to transform healthcare directly.
Innovation Through Enzyme Engineering
The use of enzymes in pharmaceuticals has been further enhanced through enzyme engineering. By employing advanced biotechnological tools such as protein engineering and directed evolution, scientists are able to modify enzymes to perform even better under industrial conditions. Engineered enzymes can withstand extreme pH levels, higher temperatures, or different solvents, broadening their utility in pharmaceutical manufacturing.
These advancements also allow the creation of entirely new enzyme activities tailored to specific processes, opening doors to innovative drug development pathways. The integration of computational modelling with enzyme design has further accelerated progress, making enzymes even more adaptable to the demands of modern pharmaceuticals.
The Future of Enzymes in Pharma
The growing reliance on enzymes is set to continue as pharmaceutical companies face the dual challenge of improving efficiency and reducing environmental impact. With the increasing complexity of modern drugs, particularly biologics, the role of enzymes will become even more critical. Biocatalysis is expected to shape not only drug manufacturing but also drug discovery, providing new tools to develop treatments that were previously out of reach.
Moreover, the adoption of enzymes aligns perfectly with the global push towards sustainability. As stakeholders demand greener processes, enzymes stand out as natural, efficient, and eco-friendly catalysts that meet both industrial and environmental goals.
Conclusion
Enzymes have firmly established themselves as indispensable tools in pharmaceutical manufacturing. Their unique ability to deliver chiral selectivity, improve yields, lower costs, and support sustainable practices has redefined the way drugs are produced. By enabling greener processes and reducing reliance on harmful chemicals, enzymes are helping the pharmaceutical industry adapt to modern challenges while ensuring the consistent supply of high-quality medicines.
At Biolaxi Enzymes, we understand the transformative power of enzymes in pharmaceutical manufacturing. With over 14 years of experience in developing high-quality, customised enzyme formulations, Biolaxi has consistently supported pharmaceutical companies in achieving excellence. Our strong focus on innovation, eco-friendly solutions, and reliable delivery makes us a trusted partner for industries worldwide. Whether it is immobilised enzymes, enzyme complexes, or customised solutions, Biolaxi continues to deliver products that align with the evolving needs of the pharmaceutical sector.
